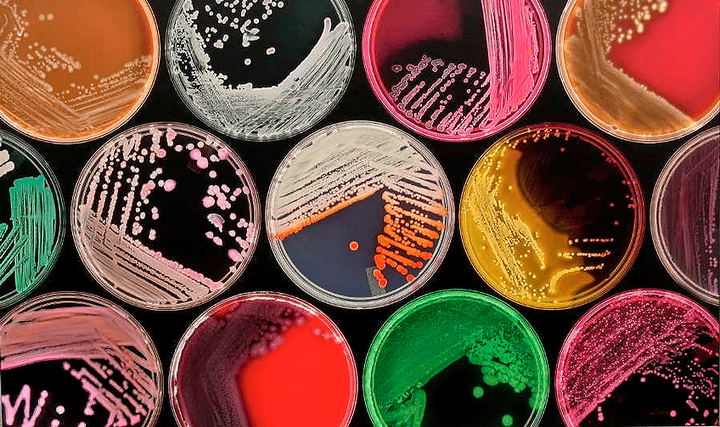
«Сопротивление бесполезно» — новые пути преодоления развития резистентности у бактерий

- Лента
- Спецпроекты
- ▶Подкаст
-
Конкурс
- О конкурсе «Био/мол/текст»
- «Био/мол/текст»-2025/2026
- «Био/мол/текст»-2024/2025
- «Био/мол/текст»-2023/2024
- «Био/мол/текст»-2022/2023
- «Био/мол/текст»-2021/2022
- «Био/мол/текст»-2020/2021
- «Био/мол/текст»-2019
- «Био/мол/текст»-2018
- «Био/мол/текст»-2017
- «Био/мол/текст»-2016
- «Био/мол/текст»-2015
- «Био/мол/текст»-2014
- «Био/мол/текст»-2013
- «Био/мол/текст»-2012
- «Био/мол/текст»-2011
- Объявления
- Авторы
- Партнеры
- Поддержать
Публикации
—
Темы
—
Авторы
—
Комментарии
—
Поиск не дал результатов
По вашему запросу ничего не найдено
- Медицина
- SARS-CoV-2
- «Биомолекула» — Forbes
- Аллергия
- Антибиотики
- Атеросклероз
- Аутоиммунитет
- Боль
- ВИЧ/СПИД
- Вакцины
- Вирус Зика
- Вирус Эбола
- Генная терапия
- Грипп
- Депрессия
- Дерматология
- Диагностика
- Здравоохранение
- Нейродегенерация
- Никотин
- Онкология
- Персонализированная медицина
- Питание
- Сон
- Стволовые клетки
- Фармакология
- Эпилепсия
- Биология
- «Сухая» биология
- Антропология
- Бионика
- Биофизика
- Вирусология
- Вопросы пола
- ГМО
- Генетика
- Иммунология
- Микробиология
- Нейробиология
- Носимые технологии
- Психогенетика
- Синтетическая биология
- Старение
- Структурная биология
- Цитология
- Эволюционная биология
- Экология
- Эмбриология
- Эпигенетика
- Этология
- Биомолекулы
- GPCR
- АФК
- Амилоиды
- Биомембраны
- Гормоны растений
- ДНК
- Ионные каналы
- МГЭ
- Матрикс
- Нейромедиаторы
- РНК
- Рецепторы
- Хроматин